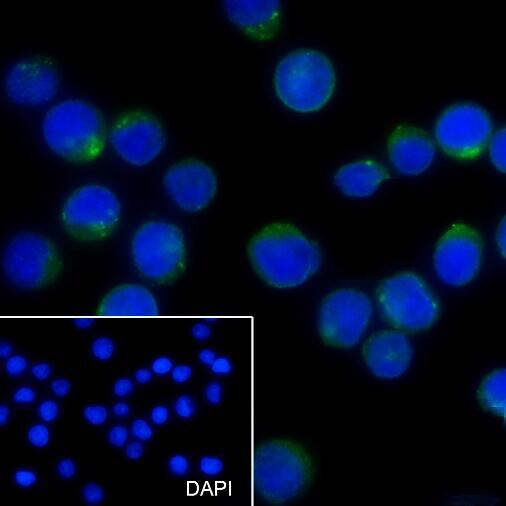

Self-ligand receptor of the signaling lymphocytic activation molecule (SLAM) family. SLAM receptors triggered by homo- or heterotypic cell-cell interactions are modulating the activation and differentiation of a wide variety of immune cells and thus are involved in the regulation and interconnection of both innate and adaptive immune response. Promotes T-cell differentiation into a helper T-cell Th17 phenotype leading to increased IL-17 secretion.
推荐稀释比 ICC/IF:1/50;FC:1/50-1/100
Immunocytochemistry analysis of CD352(green) in Ramos cells using CD352 antibody,and DAPI(blue).

Flow Cytometry analysis of PBMC stained with CD352 antibody(Red).Blue line histogram represents nonspecific negative control
Store at 4°C short term. Aliquot and store at -20°C long term. Avoid freeze/thaw cycles.
